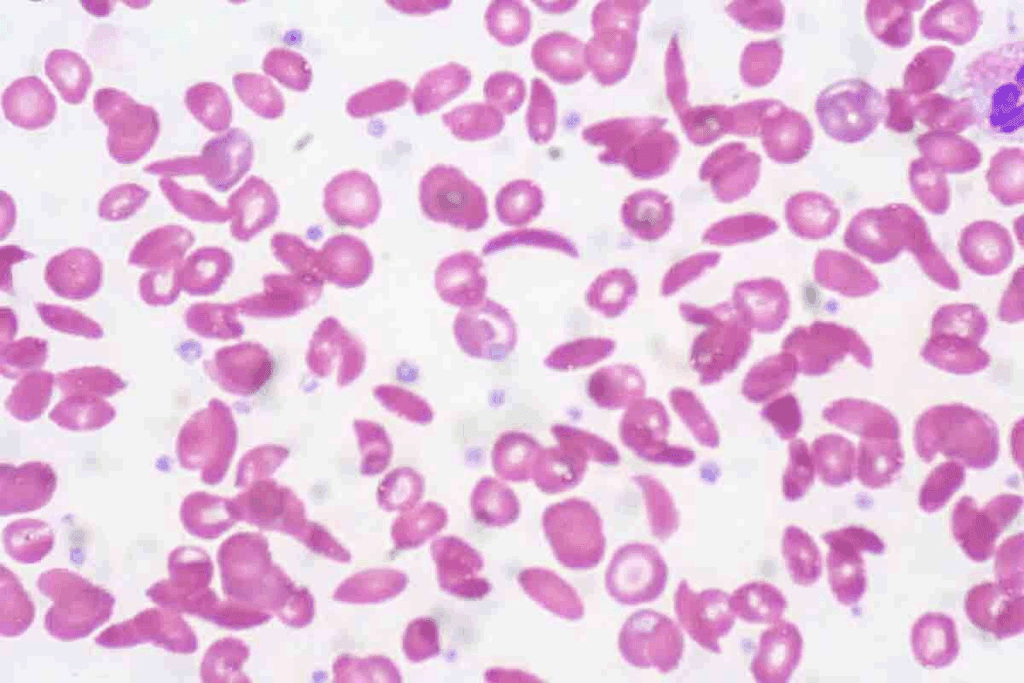
7 Key Causes of Aplastic Anemia (aplastic anemia causes): What You Need to Know

Aplastic anemia is a rare and serious condition. It happens when the bone marrow can’t make enough blood cells. This leads to severe health problems. At LivHospital, we focus on finding the aplastic anemia causes to treat it effectively.
About 65 percent of aplastic anemia cases have no known cause. But, we know many things can lead to this disorder. Our team works hard to give the best care and support to those affected by it.
Knowing the causes of aplastic anemia is key to managing it. We look into the main factors, like unknown causes, acquired, and inherited ones. This helps patients and their families deal with this tough condition.
Key Takeaways
- Understanding the causes of aplastic anemia is key to managing it.
- Aplastic anemia is a rare but serious blood disorder.
- Idiopathic cases make up about 65 percent of aplastic anemia cases.
- Many factors, including acquired and inherited ones, can cause aplastic anemia.
- LivHospital offers innovative care and support for aplastic anemia patients.
Understanding Aplastic Anemia and Its Impact

Aplastic anemia is a rare and serious condition. It affects the bone marrow’s ability to make blood cells. This leads to pancytopenia, a big drop in red, white blood cells, and platelets.
What is Aplastic Anemia?
Aplastic anemia happens when the bone marrow can’t make enough blood cells. It can be caused by toxic chemicals, viral infections, or autoimmune disorders. Symptoms include fatigue, infections, and bleeding problems.
To diagnose aplastic anemia, doctors do blood tests and a bone marrow biopsy. Knowing the cause helps choose the right treatment.
How Aplastic Anemia Affects the Body
The effects of aplastic anemia on the body are big. Pancytopenia from bone marrow failure causes:
- Fatigue and weakness from not enough red blood cells (anemia)
- More infections because of low white blood cells (leukopenia)
- Bleeding and bruising from low platelets (thrombocytopenia)
People with aplastic anemia face many complications. These can really hurt their quality of life. Getting the right treatment is key to managing these issues.
Doctors say, “Early diagnosis and treatment of aplastic anemia are critical to improving patient outcomes.” This shows how important it is to understand this condition and its effects.
The 7 Major Aplastic Anemia Causes Explained
Aplastic anemia is a complex condition with many causes. It can be divided into idiopathic and acquired forms. Knowing these causes is key to creating effective treatments and better patient outcomes.
Idiopathic vs. Acquired Forms
Aplastic anemia falls into two main types: idiopathic and acquired. Idiopathic aplastic anemia makes up about 65% of cases, with no known cause found. In contrast, acquired aplastic anemia is caused by things like toxic chemicals, drugs, and viruses.
Knowing if a case is idiopathic or acquired is important. Idiopathic cases often need a general treatment plan. But, acquired cases might be treated by fixing the cause.
Risk Factors and Prevalence
Many factors can lead to aplastic anemia. These include chemicals like pesticides, certain drugs, and viruses like hepatitis and Epstein-Barr. Knowing these risks helps prevent and catch the condition early.
The number of people with aplastic anemia varies worldwide. Some places have more cases than others. Studies show it affects different groups differently. This means we need data specific to each area to help with healthcare.
Cause #1: Toxic Chemical Exposure and Environmental Factors
Toxic chemical exposure is a big concern for aplastic anemia. Some chemicals can harm bone marrow. This can happen in work places and the environment we live in.
Chemicals like benzene and pesticides can increase the risk of aplastic anemia. Benzene, used in many industrial processes, is very harmful to bone marrow. Long-term exposure to benzene can greatly raise the risk of getting aplastic anemia.
Common Chemical Agents Linked to Bone Marrow Damage
Many chemicals can damage bone marrow and lead to aplastic anemia. These include:
- Benzene: Used in industrial processes, gasoline, and some manufacturing.
- Pesticides: Certain insecticides and herbicides have been associated with an increased risk.
- Industrial solvents: Chemicals used in cleaning and degreasing processes.
People exposed to these chemicals, often at work, need to know the risks. They should take steps to prevent harm.
Occupational Hazards and Preventive Measures
Workers in industries with these chemicals face higher risks. Occupational hazards can be lessened with safety measures and proper equipment. Employers should ensure a safe work environment. This includes training on handling dangerous chemicals and using personal protective equipment (PPE).
Preventive steps include:
- Using PPE such as gloves, masks, and protective clothing.
- Implementing engineering controls to minimize exposure.
- Regular monitoring of workplace air quality.
- Providing worker education on chemical hazards.
If you’ve been exposed to toxic chemicals and worry about aplastic anemia, see a doctor. People exposed to contaminated water, like those at Camp Lejeune, might have legal options for compensation.
Medical experts stress the importance of awareness and prevention. Knowing the risks and taking action can protect against harmful effects of toxic chemicals.
“The prevention of occupational diseases requires a multifaceted approach, including education, engineering controls, and personal protective equipment.”
Cause #2: Viral Infections and Immune System Response
We look into how viral infections, like hepatitis and Epstein-Barr virus, lead to aplastic anemia. These infections can start a complex immune reaction. This reaction might harm the bone marrow’s ability to make blood cells. Knowing this helps doctors diagnose and treat aplastic anemia better.
Hepatitis and Epstein-Barr Virus Connections
Hepatitis viruses cause liver inflammation and have been linked to aplastic anemia. The Epstein-Barr virus, which causes infectious mononucleosis, also has a connection. These viruses can start an immune response that damages the bone marrow.
Key Connections:
- Hepatitis viruses can cause aplastic anemia through immune-mediated destruction of bone marrow.
- Epstein-Barr virus infection has been reported to precede the onset of aplastic anemia in some patients.
How Viral Infections Trigger Marrow Aplasia
Viral infections can cause marrow aplasia by starting an immune response that targets the bone marrow. This response can lead to the production of cytokines and other immune factors. These factors can weaken the bone marrow’s function.
The process involves:
- Activation of immune cells in response to viral infection.
- Production of cytokines that can damage bone marrow cells.
- Suppression of bone marrow function, leading to aplasia.
The table below shows the main points about viral infections and aplastic anemia:
| Viral Infection | Association with Aplastic Anemia | Mechanism |
| Hepatitis Viruses | Documented cases of aplastic anemia following hepatitis infection. | Immune-mediated destruction of bone marrow. |
| Epstein-Barr Virus | Reported cases of aplastic anemia after Epstein-Barr virus infection. | Immune response triggering marrow aplasia. |
Cause #3: Autoimmune Disorders and Inflammatory Conditions
When the immune system attacks the bone marrow by mistake, it causes aplastic anemia. This is because the immune system is supposed to fight off germs, not attack the body’s own tissues. But in autoimmune disorders, it does just that.
When the Body Attacks Its Own Bone Marrow
Autoimmune aplastic anemia happens when the immune system attacks the bone marrow. This stops it from making blood cells. It’s because the immune system sees the bone marrow as a threat, even though it’s part of the body.
Key autoimmune conditions associated with aplastic anemia include:
- Rheumatoid arthritis
- Systemic lupus erythematosus (lupus)
- Autoimmune hemolytic anemia
These conditions cause inflammation and damage to the bone marrow. This leads to aplastic anemia. Knowing how these disorders cause aplastic anemia is key to managing it well.
Associated Autoimmune Conditions and Management
Managing autoimmune aplastic anemia means treating the autoimmune disorder and the bone marrow failure. This often involves using drugs to calm down the immune system’s attack on the bone marrow.
“Immunosuppressive therapy has become a cornerstone in the treatment of aplastic anemia, specially in cases where the condition is triggered by autoimmune disorders.”
Hematologist
The table below shows common autoimmune conditions linked to aplastic anemia and how to manage them:
| Autoimmune Condition | Management Strategy |
| Rheumatoid Arthritis | Immunosuppressive drugs, Biologic agents |
| Systemic Lupus Erythematosus | Corticosteroids, Immunosuppressants |
| Autoimmune Hemolytic Anemia | Corticosteroids, Immunosuppressive therapy |
Understanding the autoimmune conditions that cause aplastic anemia helps healthcare providers treat it better. This improves patient outcomes.
Cause #4: Medications and Radiation Exposure
Certain medications and radiation therapy can harm the bone marrow, leading to aplastic anemia. We will look into how these factors contribute to this condition.
High-Risk Medications and Drug-Induced Aplastic Anemia
Some medications can cause aplastic anemia as a rare but serious side effect. These include certain antibiotics, anticonvulsants, and anti-inflammatory drugs. The risk depends on the dose and varies from person to person.
Common high-risk medications include:
- Chloramphenicol, an antibiotic known for its association with aplastic anemia
- Anticonvulsants like carbamazepine and phenytoin
- Nonsteroidal anti-inflammatory drugs (NSAIDs) such as phenylbutazone
It’s important to closely watch patients on these medications for signs of bone marrow suppression.
Radiation, Chemotherapy, and Bone Marrow Damage
Radiation therapy and chemotherapy are known to increase the risk of aplastic anemia. High doses of radiation can damage the bone marrow, reducing blood cell production.
The effects of radiation and chemotherapy on the bone marrow can be summarized as follows:
| Treatment | Effect on Bone Marrow | Risk of Aplastic Anemia |
| High-Dose Radiation | Direct damage to bone marrow cells | High |
| Chemotherapy | Suppression of bone marrow activity | Moderate to High |
Knowing these risks is key to managing patients undergoing these treatments.
We need to be aware of the side effects of medications and radiation therapy. This is to give the best care to our patients.
Cause #5: Inherited Genetic Disorders and Congenital Forms
Inherited genetic disorders are a lesser-known but significant cause of aplastic anemia. These conditions are often present at birth. They can increase the risk of developing bone marrow failure.
Fanconi Anemia and Other Hereditary Types
Fanconi anemia is a rare genetic disorder. It is characterized by bone marrow failure, congenital abnormalities, and an increased risk of cancer. It is one of the most common inherited causes of aplastic anemia.
Other hereditary conditions, such as Dyskeratosis Congenita and Shwachman-Diamond Syndrome, also predispose individuals to bone marrow failure.
Research has shown that genetic mutations play a key role in these disorders. For instance,studies have identified several genes associated with Fanconi anemia. This highlights the complexity of these conditions.
Genetic Testing and Family Planning Considerations
Genetic testing can identify individuals at risk of inherited genetic disorders. This information is invaluable for family planning. It allows families to make informed decisions about having children.
Early diagnosis can lead to timely interventions. This can improve outcomes for individuals with these conditions.
Understanding the genetic basis of aplastic anemia is key for developing effective treatment strategies. As research advances, we can expect to see more targeted therapies. These therapies will address the root causes of these disorders.
Diagnosis and Modern Treatment Approaches
Diagnosing aplastic anemia is a detailed process. It involves several tests to check bone marrow health. We will look at how these methods and treatments have greatly helped patients.
Diagnostic Methods for Aplastic Anemia
Diagnosing aplastic anemia requires blood tests and bone marrow exams. Blood tests check for different blood cell levels. A bone marrow biopsy looks at the marrow’s cells and finds any issues.
We also check for other conditions that might cause similar symptoms. Our tools help us understand how severe aplastic anemia is. This helps us plan the best treatment.
Hematopoietic Stem Cell Transplantation
Hematopoietic stem cell transplantation (HSCT) is a cure for aplastic anemia. It replaces damaged marrow with healthy stem cells from a donor. We suggest HSCT for severe cases or when other treatments fail.
The success of HSCT depends on finding a good donor and the patient’s health. Advances in transplant techniques have made HSCT a good choice for many.
Immunosuppressive Therapy and Other Treatments
For those not suited for HSCT or with mild aplastic anemia, immunosuppressive therapy (IST) is an option. IST uses drugs to calm the immune system, helping the marrow work better.
Other treatments include supportive care like blood transfusions and antibiotics. These help manage symptoms and prevent problems. We also use growth factors to boost blood cell production.
- Immunosuppressive therapy to reduce immune system attack on bone marrow
- Supportive care to manage symptoms and prevent infections
- Growth factors to stimulate blood cell production
By using these treatments together, we can greatly improve life quality and survival rates for aplastic anemia patients.
Conclusion: Living with Aplastic Anemia
Medical treatments have made a big difference for people with aplastic anemia. But, it’s not just about treatment. It’s about ongoing care and management too. To manage aplastic anemia well, you need medical help, lifestyle changes, and support.
Those with aplastic anemia need a team of doctors to help them. Thanks to new treatments like stem cell transplants and medicines, more people are living longer. It’s important for patients and their families to know about these treatments.
Support is key for those living with aplastic anemia. This support includes medical care, mental health help, and learning how to manage the condition. With the right care and support, patients can live better lives.
We must keep researching and improving treatments for aplastic anemia. It’s also important to focus on supporting and educating patients. This way, we can help them face the challenges of this condition.
FAQ
What is aplastic anemia?
Aplastic anemia is when the bone marrow can’t make enough blood cells. This leads to symptoms like fatigue, infections, and bleeding.
What are the main causes of aplastic anemia?
Causes include idiopathic, acquired, and inherited factors. These include toxic chemicals, viral infections, autoimmune disorders, certain medications, radiation, and genetic disorders like Fanconi anemia.
How is aplastic anemia diagnosed?
Doctors use blood tests and bone marrow exams to diagnose it. They check blood cell production and look for any problems.
What is the role of toxic chemical exposure in aplastic anemia?
Exposure to harmful chemicals like benzene can damage the bone marrow. This can lead to aplastic anemia. It’s important to avoid these chemicals.
Can viral infections cause aplastic anemia?
Yes, viruses like hepatitis and Epstein-Barr can trigger an immune response. This can damage the bone marrow and cause aplastic anemia.
How do autoimmune disorders contribute to aplastic anemia?
Autoimmune disorders can make the immune system attack the bone marrow. This can lead to aplastic anemia. Managing these conditions is key to preventing it.
Are certain medications associated with an increased risk of aplastic anemia?
Yes, some medications and radiation can increase the risk of aplastic anemia. Knowing these risks is important for prevention and early detection.
What is the significance of inherited genetic disorders in aplastic anemia?
Genetic disorders like Fanconi anemia greatly increase the risk of aplastic anemia. Genetic testing and family planning are important for early intervention.
What are the modern treatment approaches for aplastic anemia?
Modern treatments include hematopoietic stem cell transplantation and immunosuppressive therapy. These have greatly improved patient outcomes.
How can patients manage and live with aplastic anemia?
Patients need ongoing care and management to live with aplastic anemia. Support and education are vital for improving quality of life.
What is the difference between aplastic anemia and aplastic crisis?
Aplastic anemia is when the bone marrow fails to produce blood cells. An aplastic crisis is a severe episode of bone marrow failure, often seen in sickle cell disease.
What is bone marrow aplasia?
Bone marrow aplasia is when the bone marrow fails to produce blood cells. This is a key feature of aplastic anemia.
Is aplastic anemia the same as anemia aplastica?
Yes, aplastic anemia and anemia aplastica are the same. Both refer to the bone marrow’s failure to produce enough blood cells.
References
- Miano, M., & Dufour, C. (2020). The diagnosis and treatment of aplastic anemia: a review. International Journal of Hematology, *111*(1), 34-44. https://pubmed.ncbi.nlm.nih.gov/31720909/